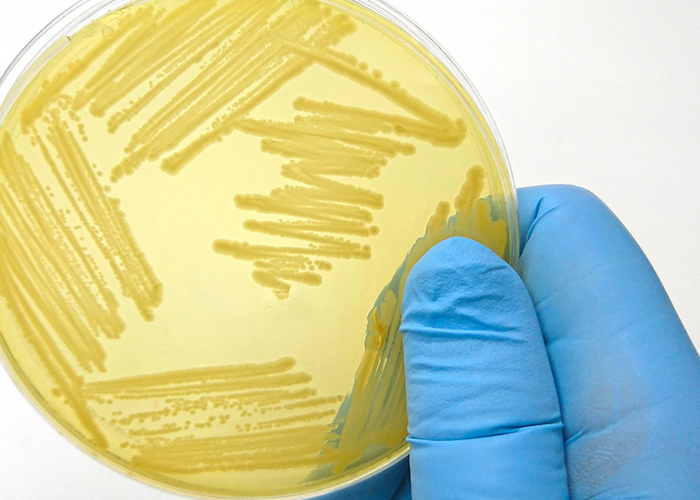
Doença de Parkinson

A vaginose bacteriana é uma condição comum entre mulheres em idade reprodutiva, caracterizada pela ausência de lactobacilos e uma comunidade diversa de bactérias anaeróbicas. Essa condição leva frequentemente ao aumento do corrimento vaginal, odor e desconforto. Além disso, a vaginose também está relacionada a vários resultados adversos à saúde presumivelmente mediados pela inflamação. Entre […]
Mês: julho 2025
O valor vital do leite
A Organização Mundial da Saúde (OMS) recomenda que os bebês sejam amamentados exclusivamente nos primeiros seis meses de vida. E, se possível, a orientação é manter o aleitamento até os dois anos de idade ou mais – mesmo depois da introdução alimentar. A recomendação se justifica porque o leite materno é o melhor alimento […]
Fundamental para a
Estudos desenvolvidos sobre o leite materno conseguiram comprovar o que, empiricamente, a humanidade já sabia desde os tempos ancestrais: é um alimento completo para a saúde dos bebês. Entretanto, as técnicas de análise mais recentes também têm ajudado a mostrar quais são os principais componentes presentes nesse alimento e de que maneira agem no […]
Zinco e LcS no perfil
1Department of Nutrition Science, Faculty of Medicine, Diponegoro University, Indonesia 2Department of Public Health Nutrition, Faculty of Public Health, Diponegoro University, Indonesia 3Nutrition Department, Health Polytechnic Makassar, Indonesia A obesidade é caracterizada pelo acúmulo excessivo de gordura decorrente de um desequilíbrio entre a ingestão e o gasto energético ao longo do tempo. A condição […]
Cirrose pode levar
Silenciosa, a cirrose é uma doença crônica e progressiva que acomete o fígado, um órgão vital para o funcionamento do corpo humano. A enfermidade é um grave problema de saúde pública global e a causa de milhares de mortes anuais, gerando grandes custos para o sistema de saúde em todo o mundo. No Brasil, […]
Jabuticaba é
Nativa da Mata Atlântica e uma das joias da flora brasileira, a jabuticaba é conhecida pelo sabor inconfundível e também pelos inúmeros benefícios oferecidos à saúde. Pertencente à família Myrtaceae e utilizada tradicionalmente na alimentação, a jabuticaba é rica em compostos bioativos, antocianinas, fibras e micronutrientes – propriedades responsáveis por conferir os efeitos antioxidantes […]
Influência de
A doença de Parkinson dobrou em prevalência nos últimos 25 anos e as estimativas globais mostram que mais de 8,5 milhões de indivíduos estão vivendo com a enfermidade. A incapacidade e a morte devido à doença também estão aumentando mais rápido em relação a qualquer outro distúrbio neurológico. Os últimos dados, publicados em 2019, […]
O poder
Mais do que melhores amigos do homem, os cães são famosos por terem um olfato extraordinário graças à sua genética e fisiologia. A literatura indica que os cachorros possuem uma capacidade olfativa que excede em até 40 vezes a observada nos humanos. Isso porque possuem 300 milhões de receptores olfativos – que se diferem […]
Parceria
A Yakult do Brasil acaba de renovar o patrocínio com a Confederação Brasileira de Desportos Aquáticos (CBDA) para todas as ações da natação brasileira, pelo quarto ano consecutivo. O novo contrato, válido até maio de 2026, envolve todas as ações da natação, inclusive os campeonatos brasileiros absolutos e de categoria que selecionam os atletas […]